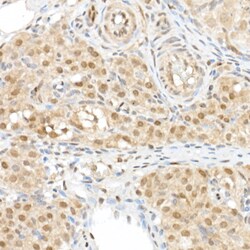
Invitrogen WWTR1 Polyclonal Antibody 100 &mu;L; Unconjugated:Antibodies,

Learn More
Invitrogen™ WWTR1 Polyclonal Antibody


Description
Positive Samples: SW480; Cellular Location: Cytoplasm, Nucleus Immunogen sequence: MNPASAPPPL PPPGQQVIHV TQDLDTDLEA LFNSVMNPKP SSWRKKILPE SFFKEPDSGS HSRQSSTDSS GGHPGPRLAG GAQHVRSHSS PASLQLGTGA GAAGSPAQQH AHLRQQSYDV TDELPLPPGW EMTFTATGQR YFLNHIEKIT TWQDPRKAMN QPLNHMNLHP AVSSTPVPQR SMAVSQPNLV MNHQHQQQMA PSTLSQQNHP TQNPPAGLMS MPNALTTQQQ.

Specifications
Specifications
| Antigen | WWTR1 |
| Applications | ELISA, Immunohistochemistry (Paraffin), Western Blot, Immunocytochemistry |
| Classification | Polyclonal |
| Concentration | 0.88 mg/mL |
| Conjugate | Unconjugated |
| Formulation | PBS with 50% glycerol and 0.02% sodium azide; pH 7.3 |
| Gene | WWTR1 |
| Gene Accession No. | Q9EPK5, Q9GZV5 |
| Gene Alias | 2310058J06Rik; 2610021I22Rik; C78399; DKFZp586I1419; FLJ27004; FLJ45718; Tafazzin; TAZ; transcriptional coactivator with PDZ binding motif; transcriptional co-activator with PDZ-binding motif; transcriptional coactivator with PDZ-binding motif; transcriptional co-activator with PDZ-binding motif (TA)Z; transcriptional co-activator with PDZ-binding motif (TAZ); WW domain containing transcription regulator 1; WW domain-containing transcription regulator protein 1; Wwtr1 |
| Gene Symbols | WWTR1 |
| Show More |
By clicking Submit, you acknowledge that you may be contacted by Fisher Scientific in regards to the feedback you have provided in this form. We will not share your information for any other purposes. All contact information provided shall also be maintained in accordance with our Privacy Policy.